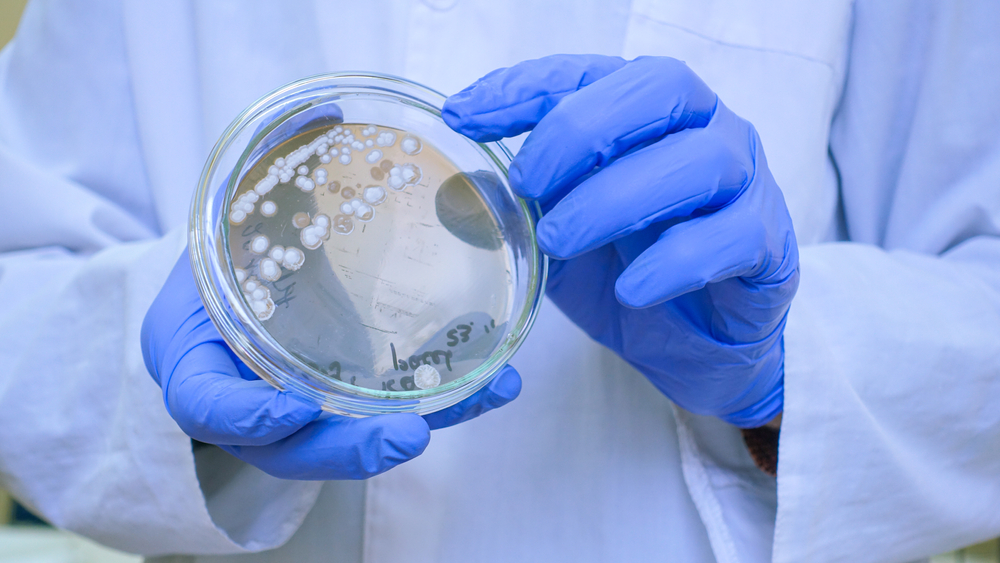
Prrrettty / Shutterstock

26 új baktériumfajt fedezett fel a NASA
Még a Föld legtisztább helyein is utat talál magának az élet – erre szolgáltat újabb bizonyítékot az a kutatás, amelyben tudósok 26 eddig ismeretlen baktériumfajt azonosítottak a NASA floridai Kennedy Űrközpontjának tisztaszobáiban. Ezekben a steril környezetekben állították össze többek között a Phoenix Mars-szondát is, ezért a helyiségeket kifejezetten úgy tervezték, hogy a legellenállóbb földi mikrobák se élhessenek túl bennük.
A felfedezés még a kutatókat is meglepte. A vizsgálatok szerint a baktériumok rendkívül kis számban voltak jelen, mégis hosszú időn át fenn tudtak maradni több különböző tisztaszobában, annak ellenére, hogy folyamatos vegyszeres takarításnak, UV-fénynek, szűrt levegőnek és extrém tápanyaghiánynak voltak kitéve. A kutatók szerint ez egyértelmű figyelmeztetés arra, hogy még a legszigorúbb bolygóvédelmi protokollokat is érdemes időről időre újragondolni.
A baktériumokat még 2007-ben gyűjtötték be a Phoenix szonda összeszerelése során: a padlókról összesen 215 mintát konzerváltak. Akkoriban azonban még nem állt rendelkezésre az a fejlett DNS-szekvenálási technológia, amely ma már lehetővé teszi új fajok nagy pontosságú azonosítását. A mostani elemzések kimutatták, hogy ezek a mikrobák olyan genetikai tulajdonságokkal rendelkeznek, amelyek segítik őket a fertőtlenítőszerekkel szembeni ellenállásban, a sugárzás okozta DNS-károsodások javításában, biofilmek képzésében vagy akár tartós nyugalmi állapot kialakításában.

A felfedezés nemcsak bolygóvédelmi szempontból fontos. A kutatók szerint ezek az extrém körülményekhez alkalmazkodott baktériumok ideális tesztalanyok lehetnek a jövő sterilizálási módszereinek ellenőrzésére, sőt egyes tulajdonságaik akár a biotechnológia vagy az orvostudomány számára is hasznosíthatók lehetnek, írja a Live Science.
A következő lépés egy különleges „bolygószimulációs kamra” megépítése, ahol a baktériumokat Mars-szerű és űrbéli körülményeknek teszik ki. A tervek szerint a kísérletek 2026 elején indulnak, és választ adhatnak arra, hogy az ezekhez hasonló mikrobák elméletben képesek lennének-e túlélni egy marsi expedíciót – és ezzel akaratlanul is szennyezni egy idegen világot.
Olvasd el ezt is!